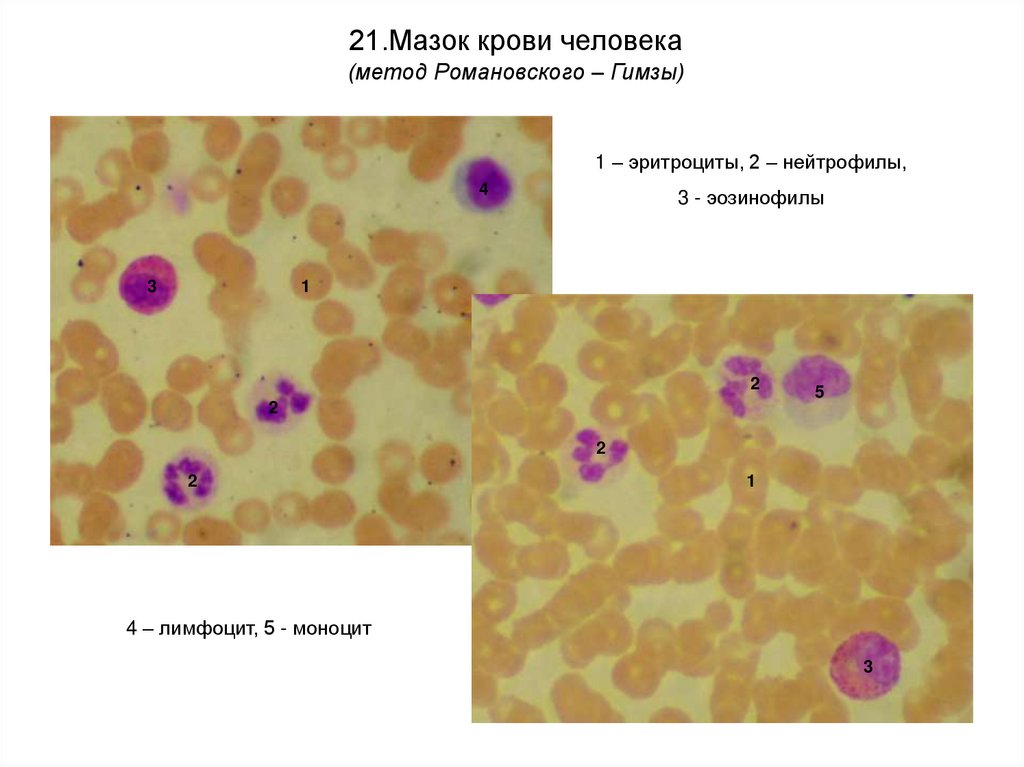

Похожие презентации:
Общая гистология ( учение о тканях )
1. Министерство здравоохранения и социального развития РФ ГОУ ВПО «Ижевская государственная медицинская академия» Лабораторный
практикумпо гистологии
(учебное пособие)
Ижевск - 2011
2. УДД 611-018(076.5) ББК 28.706я73
Авторы:И.В. Титова, Г.В. Шумихина, Т.Г. Глушкова
Рецензенты:
Д.м.н., профессор Л.С. Исакова,
Д.б.н., профессор Л.И. Растегаева
Л 125 Лабораторный практикум по гистологии: электронное учебное
пособие / И.В. Титова, Г.В. Шумихина, Т.Г. Глушкова. – Ижевск, 2011
Электронное учебное пособие подготовлено в соответствии с
Примерной программой по дисциплине гистология, эмбриология и
цитология (Москва, 2002), и перечнем основных микропрепаратов,
рекомендуемых для изучения студентами.
Учебное пособие рекомендуется для самоконтроля при подготовке
к итоговым занятиям и экзамену по гистологии и включает фотографии
с микропрепаратов, изучаемых студентами на лабораторных занятиях.
Предназначено для самостоятельной аудиторной и внеаудиторной
работы студентов лечебного и педиатрического факультетов
3.
Уважаемые студенты!Диагностика микропрепаратов является необходимым элементом
врачебных знаний. Описание препаратов представляют врачу-клиницисту
цитологические, патологоанатомические, гематологические лаборатории. Врач
должен понять представленный медицинский документ и использовать его для
постановки диагноза. Основы диагностики микропрепаратов закладываются в
ходе изучения гистологии, эмбриологии и цитологии, где студент должен
овладеть умением микроскопировать гистологические, гистохимические и
эмбриологические препараты, идентифицировать органы, ткани, их клеточные
и неклеточные структуры на микроскопическом уровне.
Для анализа микропрепаратов удобно пользоваться следующими схемами.
Схема описания микропрепарата по общей гистологии:
1.
Определите ткань или ткани на препарате, метод окраски. Дайте название
препарата.
2.
Укажите структуры, которые подтверждают ваш вывод о типе ткани.
Схема описания микропрепарата по частной гистологии:
1.
Определите тип органа (паренхиматозный или полый), метод окраски.
2.
Выделите специфические для данного органа структуры. Назовите орган.
3.
Определите структурные компоненты и тканевой состав органа.
В данном пособии представлены фотографии микропрепаратов, которые
изучаются на практических занятиях и предлагаются для диагностики на
экзамене по гистологии. Большинство препаратов даны как на малом, так и на
большом увеличении. Переключение слайдов осуществляется с помощью
клавиш «space» или «enter». Название препарата, метод окраски и
обозначения структур вызываются повторным нажатием клавиши для того,
чтобы вы могли проверить свои знания.
4.
5.
1.Накопление краски макрофагами (гистиоцитами)соединительной ткани
(трипановый синий-кармин)
1
1
1 – макрофаги с включениями трипанового синего в цитоплазме
6.
2.Многослойный неороговевающий эпителий нижней поверхности языка(гематоксилин – эозин)
3
2
1
4
1 – базальный слой эпителия, 2 – промежуточный слой эпителия, 3 –
поверхностный слой эпителия, 4 – рыхлая соединительная ткань
7.
3.Мезотелий – однослойный плоский эпителий (тотальный препарат)(импрегнация серебром)
1
1
1
1 – плазмолеммы соседних эпителиальных клеток, образующие интердигитации
8.
4.Переходный эпителий мочевого пузыря(гематоксилин – эозин)
3
2
1
4
Слои эпителия: 1 – базальный, 2 – промежуточный, 3 – поверхностный (покровный);
соединительная ткань (4)
9.
5.Многослойный плоский ороговевающий эпителий кожи пальца(гематоксилин – эозин)
1
2 3
4
5
6
Слои эпидермиса: 1 – роговой, 2 – блестящий, 3 – зернистый, 4 – шиповатый, 5 – базальный;
соединительная ткань (6)
10.
6.Рыхлая соединительная ткань(железный гематоксилин)
3
1
1
4
2
2
2
1 – фибробласты, 2 – тучные клетки, 3
– коллагеновые волокна,
4
– аморфное вещество
11.
7.Рыхлая соединительная ткань(железный гематоксилин)
1
1
1
2
1 – макрофаги, 2 - фиброцит
12.
8.Плотная неоформленная соединительная ткань кожи пальца(гематоксилин – пикрофуксин)
2
1
3
1 – эпидермис, 2 – плотная неоформленная соединительная ткань, 3 – жировая ткань
13.
9.Сухожилие в продольном срезе(гематоксилин – эозин)
1 – фиброциты,
2 – коллагеновые волокна,
3 - эндотеноний
5
3
4 – сухожильный пучок 1 порядка,
2
4
2
5 - сухожильный пучок 2 порядка
1
4
14.
10.Гиалиновый хрящ(гематоксилин – эозин)
1
2
3
3
5
4
2
1 – надхрящница, 2 – зона молодого хряща, 3 – зона зрелого хряща,
4 – изогенная группа хондроцитов, 5 – межклеточное вещество
15.
11.Эластический хрящ(гематоксилин – орсеин)
2
1
1
1 – хондроциты в лакунах, 2 – межклеточное вещество с эластическими волокнами
16.
12.Развитие костной ткани из мезенхимы (прямой остеогенез)(гематоксилин – эозин)
2
4
3
1
6
1
1
6
3
2
5
3
4
6
1 – костные балки, 2 – мезенхима, 3 – кровеносные сосуды,
4 – остеобласты, 5 – остеоциты, 6 - остеокласты
17.
13.Развитие костной ткани на месте хряща (непрямой остеогенез)(гематоксилин – эозин)
3
2
1
4
5
1 – надкостница, 2 – костная ткань,
3 – остеокласт, 4 – столбчатый
хрящ, 5 – пузырчатый хрящ
18.
14.Поперечный срез берцовой кости(метод Шморля – тионин, пикриновая кислота)
1 – остеоны, 2 – канал остеона,
3 - кровеносный сосуд, 4 – остеоциты,
5
5 – вставочные пластинки
1
1
4
3
2
19.
15.Ретикулярная ткань лимфатического узла(гематоксилин-эозин)
2
2
1
1
1
2
1
1 – ретикулярные клетки, 2 - лимфоциты
20.
16.Скелетная мышечная ткань(железный гематоксилин)
4
4
1
2
1
3
1 – мышечные волокна
(миосимпласты), 2 – ядра
миосимпласта, 3 – эндомизий,
4 - перимизий
21.
17.Сердечная мышечная ткань(железный гематоксилин)
2
2
1
1
3
3
2
1 – ядра кардиомиоцитов, 2 – вставочные диски,
3 – соединительная ткань с кровеносными капиллярами
22.
18.Базофильное вещество в нейронах(толуидиновый синий)
1
2
3
4
1
5
5
1 – мультиполярные нейроны, 2 - ядро с ядрышком, 3 - цитоплазма с глыбками
базофильного вещества, 4 - аксонный холмик, 5 – ядра глиоцитов
23.
19.Миелиновые нервные волокна(импрегнация осмием)
4
2
1
3
1 – перехват Ранвье, 2 – насечка,
3 – осевой цилиндр, 4 - миелин
24.
20.Безмиелиновые нервные волокна(гематоксилин – эозин)
2
1
2
1
2
1 – осевые цилиндры (отростки нейронов), 2 – ядра леммоцитов
25.
21.Мазок крови человека(метод Романовского – Гимзы)
1 – эритроциты, 2 – нейтрофилы,
4
3
3 - эозинофилы
1
2
5
2
2
2
1
4 – лимфоцит, 5 - моноцит
3
26.
22.Мазок крови человека(метод Романовского – Гимзы)
Юный нейтрофил
Палочкоядерный нейтрофил
Сегментоядерный
нейтрофил
Базофил
Эозинофил
Лимфоциты
Моноцит
27.
23.Мазок красного костного мозга(метод Романовского – Гимзы)
Эозинофильный
миелоцит
Нейтрофильный
метамиелоцит
Базофильный
проэритроцит
Полихроматофильный
проэритроцит
Миелоцит
28. 24.Сперматозоиды человека (гематоксилин – эозин)
29.
30.
25.Артерия эластического типа – аортаСердечно-сосудистая
система
(орсеин)
3
1
2
1 – средняя оболочка, 2 – наружная оболочка аорты, 3 – эластические окончатые мембраны
31.
26.Артерия мышечного типа(гематоксилин-эозин)
Сердечно-сосудистая
система
1
2
3
1 – внутренняя оболочка, 2 – средняя оболочка
(гладкомышечные клетки и эластические волокна),
3 – наружная оболочка (адвентиция) артерии
32.
27.ВенаСердечно-сосудистая система
(гематоксилин-эозин)
1
2
3
1 – внутренняя оболочка, 2 – средняя оболочка, 3 – наружная оболочка вены
33.
Сердечно-сосудистая система28.Артериолы, венулы и капилляры мягкой мозговой оболочки
(гематоксилин – эозин)
3
1
2
3
2
1 – артериола, 2 – венула, 3 – ядра гладкомышечных клеток
34.
Сердечно-сосудистая система29.Волокна Пуркинье проводящей системы сердца
(гематоксилин – эозин)
3
1
3
2
1 – эндокард, 2 – сократительные кардиомиоциты, 3 – кардиомиоциты проводящей
системы сердца (волокна Пуркинье)
35.
Иммунная система30.Тимус
(гематоксилин – эозин)
3
1
4
2
Тельце тимуса в
мозговом веществе
1 – корковое вещество, 2 – мозговое вещество, 3 – капсула тимуса, 4 – междольковая
соединительнотканная перегородка
36.
Иммунная система31.Лимфатический узел
(гематоксилин – эозин)
4
6
1
2
8
4
5
3
5
7
4
1 – корковое вещество, 2 – мозговое вещество, 3 – капсула, 4 – лимфоидные фолликулы,
5 – мозговые тяжи, 6 – краевой синус, 7 – корковый синус, 8 – мозговой синус
37.
32.СелезенкаИммунная система
(гематоксилин – эозин)
1
2
3
4
1
1
5
1 – белая пульпа (лимфоидные узелки), 2 – красная пульпа, 3 – центральная артерия узелка,
4 – соединительнотканная трабекула с веной безмышечного типа, 5 – капсула селезенки
38.
Иммунная система33.Небная миндалина
(гематоксилин – эозин)
2
1
2
1 – крипта, 2 – лимфоидные фолликулы
39.
Нервная система34.Кора больших полушарий
(импрегнация серебром)
3
1
4
5
2
6
7
1 – кора больших полушарий (серое вещество), 2 – белое вещество, слои коры (за исключением
молекулярного): 3 – наружный зернистый, 4 – пирамидный, 5 – внутренний зернистый, 6 –
ганглионарный (гигантские пирамидные клетки Беца), 7 – слой полиморфных клеток
40.
35.МозжечокНервная система
(импрегнация серебром)
5
1
2
3
4
1 – молекулярный слой, 2 – ганглионарный слой, 3 – зернистый слой коры
мозжечка, 4 – белое вещество, 5 – мягкая мозговая оболочка
41.
36.Спинной мозгНервная система
(импрегнация серебром)
4
2
3
6
1
6
5
1 – передний рог, 2 – задний рог, 3 – боковой рог, 4 – белое вещество, 5 - глиальные тяжи,
– нейроны двигательных ядер переднего рога,
6
42.
37.Спинномозговой узелНервная система
(гематоксилин – эозин)
4
2
2
3
3
2
1
1 – капсула узла, 2 – чувствительные нейроны, 3 – капсула нейрона со слоем мантийных
глиоцитов и волокнистым слоем, 4 – нервные волокна
43.
Нервная система38.Симпатический ганглий
(импрегнация серебром)
3
1
1 – мультиполярный нейрон,
2 – нервные волокна,
3 – глиальные клетки
2
44.
39.Нерв в поперечном срезеНервная система
(импрегнация осмием)
4
1
2
1
3
1
2
3
1 – миелиновые нервные волокна, 2 – безмиелиновые нервные волокна, 3 – эндоневрий, 4
- периневрий
45.
40.Задняя стенка глазаОрганы чувств
(гематоксилин – эозин)
3
2
10 9
8
7 6
5
4
1
11
1 – склера, 2 – сосудистая оболочка, слои сетчатки: 3 – пигментный слой, 4 – слой палочек и
колбочек, 5 – наружный ядерный слой, 6 – наружный сетчатый слой, 7 - внутренний ядерный слой, 8
– внутренний сетчатый слой, 9 – ганглионарный слой, 10 - слой нервных волокон, 11 – внутренняя
пограничная мембрана
46.
Органы чувств41.Роговица
(гематоксилин – эозин)
5
4
3
2
1
1 – передний эпителий, 2 – передняя пограничная мембрана, 3 – соединительнотканная
основа, 4 – задняя пограничная мембрана, 5 - задний эпителий роговицы
47.
42.Орган слуха (спиральный, кортиев орган)Органы чувств
(гематоксилин – эозин)
5
2
4
2
6
5
7
4
9
3
6
10
9
1
8
3
1 – стержень улитки, 2 – вестибулярная лестница, 3 - барабанная лестница,
– перепончатый канал улитки, 5 – вестибулярная мембрана, 6 – спиральная связка,
сосудистая полоска, 8 – базилярная пластинка, 9 – спиральный ганглий,
спиральный орган
4
7–
10 –
48.
43.Орган слуха (спиральный, кортиев орган)(гематоксилин – эозин)
7
3
2
5
1
4
6
4
1 – туннель, 2 – наружные волосковые клетки, 3 – внутренние волосковые
клетки, 4 – клетки-столбы, 5 – внутренние поддерживающие клетки, 6 –
наружные поддерживающие клетки, 7 – покровная мембрана
Органы чувств
49.
Органы чувств44.Листовидные сосочки языка, вкусовые почки
(гематоксилин – эозин)
5
4
2
3
4
2
5
1
1 – многослойный неороговевающий эпителий листовидного сосочка, 2 – вкусовые
почки, 3 – вкусовая пора, 4 – сенсоэпителиальные клетки, 5 – поддерживающие клетки
50.
45.ГипоталамусЭндокринная система
(гематоксилин-эозин)
1 – зрительный перекрест,
2 – супраоптическое ядро
1
1
2
2
3
3
3 – секреторные нейроны
51.
46.Гипофиз человекаЭндокринная система
(метод Маллори)
3
4
4
2
1
5
6
5
7
3
1 – аденогипофиз, 2 – нейрогипофиз, 3 – псевдофолликулы, 4 – оксифильные эндокриноциты,
5 - базофильные эндокриноциты, 6 - хромофобные эндокриноциты, 7 - капилляр
52.
Эндокринная система47.Надпочечник
железный гематоксилин
гематоксилин - эозин
капсула
1
1
Корковое
2
вещество
3
2
3
Мозговое
4
вещество
4
1 – клубочковая зона, 2 – пучковая зона, 3 – сетчатая зона, 4 – кровеносные капилляры
53.
Эндокринная система48.Щитовидная железа
(гематоксилин – эозин)
4
1
2
3
1
1 – фолликулы, 2 – тироциты, 3 – тироглобулин, 4 – интерфолликулярный эпителий
54.
49.Паращитовидная железа(гематоксилин – эозин)
1
2
2
1 – прослойки соединительной ткани, 2 - тяжи паратироцитов
Эндокринная система
55.
50.СеменникМужская половая система
(гематоксилин – эозин)
8
3
4
1
6
2
1
4
3
5
4
7
2
1 – извитые канальцы, 2 – интерстиций,
3 – сперматогонии, 4 – сперматоциты,
5 – сперматиды, 6 – сперматозоиды, 7 – клетки
Сертоли (сустентоциты), 8 – клетки Лейдига
56.
51.Придаток семенникаМужская половая система
(гематоксилин – эозин)
Проток придатка
Выносящие
канальцы
57.
52.Предстательная железаМужская половая система
(гематоксилин – эозин)
1
2
3
4
1 – капсула, 2 – соединительнотканная строма, 3 – уретра,
4 – междольковые выводные протоки, 5 – секреторные отделы
5
5
58.
53.ЯичникЖенская половая система
(гематоксилин – эозин)
1
5
4
3
7
8
2
11
12
11
6
7
5
10
10
10 9
7
12
8
1 – белочная оболочка, 2 – корковое вещество, 3 – мозговое вещество, 4 – примордиальные фолликулы,
5 – первичные фолликулы, 6 – вторичные фолликулы, 7 – третичные фолликулы, 8 – тека, 9 –
яйценосный бугорок, 10 – овоциты, 11 – атретическое тело, 12 – белое тело
59.
Женская половая система54.Яйцевод (маточная труба)
(гематоксилин-эозин)
1
2
3
1 – слизистая оболочка, 2 – мышечная оболочка, 3 – серозная оболочка
60.
Женская половая система55. Матка
(гематоксилин – эозин)
5
2
3
6
1
4
1 – слизистая оболочка (эндометрий), 2 – функциональный слой эндометрия,
3 – базальный слой эндометрия, 4 - мышечная оболочка (миометрий),
– сосудистый слой миометрия, 6 – серозная оболочка (периметрий)
5
61.
Женская половая система56.Молочная железа
(гематоксилин – эозин)
2
1
4
1
3
3
4
1
2
1 – концевые секреторные отделы, 2 – внутридольковые выводные протоки,
3 – междольковые выводные протоки, 4 – междольковая соединительная ткань
62.
Эмбриология57.Срез зародыша курицы на стадии осевого комплекса
зачатков органов (гематоксилин – эозин)
1
1
3
5
5
6
9
7
6
9
4
8
7
8
2
1 – эктодерма, 2 – энтодерма, 3 – нервная трубка, 4 – хорда, 5 – сомиты, 6 – нефротом,
7
– целом, 8 – висцеральный листок спланхнотома, 9 – париетальный листок спланхнотома
63.
Эмбриология58.Плацента
(гематоксилин – эозин)
плодная часть
материнская часть
3
5
1
5
3
4
3
6
3
4
2
1 – амнион, 2 – пластинка хориона, 3 – ворсинки хориона, 4 – фибриноид, 5 – лакуны с
кровью матери, 6 – базальный слой эндометрия с децидуальными клетками
64.
59.ГубаПищеварительная
система
(гематоксилин-эозин)
Промежуточный отдел (красная кайма)
Слизистый отдел
Кожный отдел
65.
60.Щека (слизистый отдел)Пищеварительная
система
(гематоксилин-эозин)
1
2
3
4
1 – многослойный неороговевающий эпителий, 2 – собственная пластинка слизистой,
3 – жировая ткань, 4 – слюнные железы в подслизистой основе
66.
61.Околоушная слюнная железаПищеварительная
система
(гематоксилин-эозин)
5
1
4
2
5
3
1
1 – белковые секреторные отделы, 2 – вставочный выводной проток,
– исчерченный выводной проток, 4 – междольковый выводной проток,
междольковая соединительная ткань
3
5–
67.
Пищеварительнаясистема
62.Подчелюстная слюнная железа
(гематоксилин-эозин)
6
1
2
5
5
4
1
3
1
3
2
2
1 – белковый секреторный отдел, 2 – смешанный секреторный отдел, 3 – белковое полулуние, 4 –
вставочный выводной проток, 5 – исчерченный выводной проток, 6 – междольковый выводной проток
68.
Пищеварительнаясистема
63.Подъязычная слюнная железа
(гематоксилин-эозин)
1
5
6
2
4
2
3
1 – белковый секреторный отдел, 2 – слизистый секреторный отдел, 3 – смешанный секреторный
отдел, 4 – белковое полулуние, 5 – вставочный выводной проток, 6 – междольковый выводной проток
69.
64.Развитие зуба, эмалевый органПищеварительная
система
(гематоксилин – эозин)
3
1
2
1
5
2
4
1 – наружный эпителий эмалевого органа, 2 – внутренний эпителий эмалевого органа,
3 – пульпа эмалевого органа, 4 – зубной сосочек, 5 – зубной мешочек
70.
65.Развитие зуба, образование дентина и эмалиПищеварительная
система
(гематоксилин – эозин)
1
1 – наружный эпителий эмалевого органа,
2 – пульпа эмалевого органа,
3 – закладка пульпы зуба,
2
3
5
4
7
8
4 – амелобласты, 5 – эмаль,
6 – дентин, 7 – предентин,
8 - дентинобласты
6
71.
Пищеварительнаясистема
66.Шлиф зуба
(не окрашен)
дентин
эмаль
дентин
цемент
72.
67.Срез зубаПищеварительная
система
(пикриновая кислота)
дентин с дентинными
канальцами
альвеолярная кость
дентин
73.
Пищеварительнаясистема
68.Пищевод
(гематоксилин – эозин)
2
1
3
4
8
5
6
7
1 – многослойный неороговевающий эпителий слизистой оболочки, 2 - собственная пластинка
слизистой оболочки, 3 - мышечная пластинка слизистой оболочки, 4 – подслизистая основа,
5 – выводные протоки желез пищевода, 6 – секреторные отделы желез, 7 – мышечная оболочка,
8 – адвентициальная оболочка
74.
Пищеварительнаясистема
69.Переход пищевода в желудок
(гематоксилин – эозин)
1
2
2
3
4
1 – место перехода пищевода в желудок, 2 – желудочные ямки,
3 – железы пищевода, 4 – железы желудка
75.
70.Дно желудкаПищеварительная
система
(гематоксилин – конго красный)
4
1
5
6
8
7
2
3
1 – слизистая оболочка, 2 - подслизистая основа, 3 – мышечная оболочка, 4 – желудочные ямки,
– фундальные железы, 6 – париетальные экзокриноциты, 7 – главные экзокриноциты,
мышечная пластинка слизистой оболочки
5
8–
76.
Пищеварительнаясистема
71.Пилорическая часть желудка
(гематоксилин-эозин)
4
1
4
5
5
6
2
3
1 – слизистая оболочка, 2 – подслизистая основа, 3 – мышечная оболочка, 4 – желудочные
ямки, 5 – пилорические железы, 6 – мышечная пластинка слизистой оболочки
77.
Пищеварительнаясистема
72.Тонкая кишка
(гематоксилин – эозин)
1
1
5
2
6
3
4
1 – ворсинка, 2 – крипты, 3 – подслизистая основа, 4 – мышечная оболочка,
– каемчатые энтероциты, 6 – бокаловидные энтероциты
5
78.
73.Толстая кишкаПищеварительная
система
(гематоксилин-эозин)
1
2
5
3
6
4
1 – слизистая оболочка, 2 – подслизистая основа, 3 – мышечная оболочка, 4 – серозная
оболочка, 5 – крипта, 6 – мышечная пластинка слизистой оболочки
79.
74.Печень человекаПищеварительная
система
(гематоксилин – эозин)
в
3
2
а
б
4
1
1 – центральная вена, 2 – триада: а – вена, б – артерия, в – желчный проток,
3 – поддольковая вена, 4 – синусоидный капилляр
80.
75.Поджелудочная железаПищеварительная
система
(гематоксилин – эозин)
3
2
4
5
1
1 – секреторный отдел (ацинус) экзокринной
части железы, 2 – центроацинозная клетка,
3 – базофильная зона ацинуса, 4 – оксифильная
зона ацинуса, 5 – островок Лангерганса
эндокринной части железы
81.
76.Почка, корковое веществоВыделительная система
(гематоксилин – эозин)
5
4
2
1
6
5
3
2
1 – сосудистый клубочек почечного
тельца, 2 – просвет капсулы клубочка,
3 – приносящая артериола, 4 – плотное
пятно, 5 – проксимальный каналец,
6 – дистальный каналец
82.
Выделительная система77.Почка, мозговое вещество
(гематоксилин – эозин)
1
3
2
2
3
1 – собирательная трубочка, 2 – тонкий каналец нефрона, 3 - капилляры
83.
78.Мочевой пузырьВыделительная система
(гематоксилин-эозин)
1
2
3
4
1 - переходный эпителий
слизистой оболочки,
2 – собственная пластинка
слизистой оболочки,
3 – подслизистая основа,
4 – мышечная оболочка
84.
Выделительная система79.Мочеточник
(гематоксилин – эозин)
1
2
3
4
5
1 - переходный эпителий слизистой оболочки, 2 – собственная пластинка слизистой
оболочки, 3 – подслизистая основа, 4 – мышечная оболочка, 5 – серозная оболочка
85.
80.ТрахеяДыхательная система
(гематоксилин – эозин)
1
2
3
8
4
5
6
7
1 - слизистая оболочка, 2 – многорядный мерцательный эпителий, 3 – собственная пластинка, 4
– мышечная пластинка слизистой, 5 - подслизистая основа, 6 – фиброзно-хрящевая оболочка, 7
– адвентициальная оболочка, 8 – железы трахеи
86.
81.Легкое, крупный бронхДыхательная система
(гематоксилин – эозин)
5
4
6
5
1
2
3
4
1 – мерцательный эпителий, 2 – собственая пластинка слизистой оболочки,
– мышечная пластинка слизистой оболочки, 4 – железы в подслизистой основе,
пластинки гиалинового хряща, 6 – адвентициальная оболочка
3
5–
87.
82.Легкое(гематоксилин – эозин)
Мелкий бронх
Респираторная бронхиола
Ацинус легкого
Альвеолярный ход
88.
Кожа и ее производные83.Кожа пальца
(гематоксилин – эозин)
эпидермис
4
1
4
3
5
гиподерма
дерма
2
1 – сосочковый слой дермы,
2 – сетчатый слой дермы,
3 – концевой отдел потовой
железы, 4 – выводной
проток потовой железы,
5 – жировая ткань
89.
84.Кожа с волосомКожа и ее производные
(гематоксилин – эозин)
1
9
2
10
8
5
11
9
6
7
3
4
1 – эпидермис, 2 – дерма,
3 – волосяная луковица,
4 – волосяной сосочек,
5 – наружное корневое
влагалище,
6 – внутреннее корневое
влагалище,
7 – волосяная сумка,
8 – потовая железа,
9
- концевой отдел сальной
железы,
10 –
выводной проток сальной
железы,
11 –
мышца, поднимающая
волос

Биология
Биология








